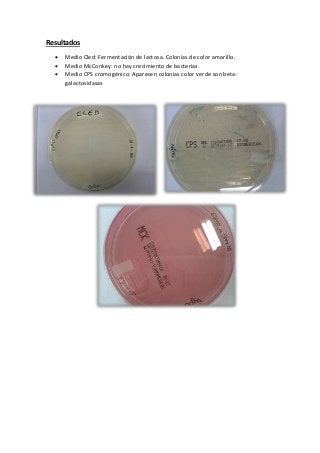
Resultados
 Medio Cled: Fermentación de lactosa. Colonias de color amarillo.
 Medio McConkey: no hay crecimiento de bacterias
 Medio CPS cromogénico: Aparecen colonias color verde son beta-
galactosidasas
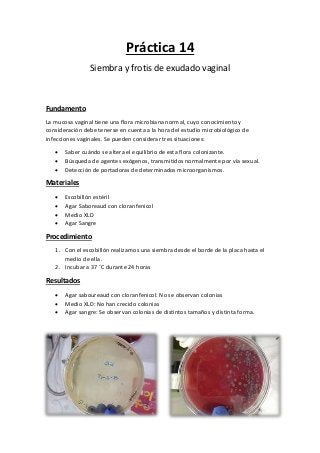
Práctica 14
Siembra y frotis de exudado vaginal
Fundamento
La mucosa vaginal tiene una flora microbiana normal, cuyo conocimiento y
consideración debe tenerse en cuenta a la hora del estudio microbiológico de
infecciones vaginales. Se pueden considerar tres situaciones:
 Saber cuándo se altera el equilibrio de esta flora colonizante.
 Búsqueda de agentes exógenos, transmitidos normalmente por vía sexual.
 Detección de portadoras de determinados microorganismos.
Materiales
 Escobillón estéril
 Agar Saboreaud con cloranfenicol
 Medio XLD
 Agar Sangre
Procedimiento
1. Con el escobillón realizamos una siembra desde el borde de la placa hasta el
medio de ella.
2. Incubar a 37 ˚C durante 24 horas
Resultados
 Agar saboureaud con cloranfenicol: No se observan colonias
 Medio XLD: No han crecido colonias
 Agar sangre: Se observan colonias de distintos tamaños y distinta forma.
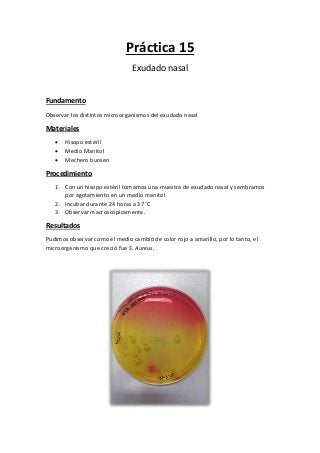
Práctica 15
Exudado nasal
Fundamento
Observar los distintos microorganismos del exudado nasal
Materiales
 Hisopo estéril
 Medio Manitol
 Mechero bunsen
Procedimiento
1. Con un hisopo estéril tomamos una muestra de exudado nasal y sembramos
por agotamiento en un medio manitol
2. Incubar durante 24 horas a 37 ˚C
3. Observar macroscópicamente.
Resultados
Pudimos observar como el medio cambió de color rojo a amarillo, por lo tanto, el
microorganismo que creció fue S. Aureus.

Este documento presenta un resumen de 15 prácticas de microbiología realizadas durante el segundo trimestre. Las prácticas incluyen siembras de anaerobios, pruebas como RPR-carbón y TPHA para diagnóstico de sífilis, antibiogramas, urocultivo, coprocultivo, pruebas para rotavirus y adenovirus, siembra de mohos, test de filamentación para Candida albicans y serodiagnóstico de toxoplasmosis. Para cada práctica se describe el fundamento, materiales, muestra y proced